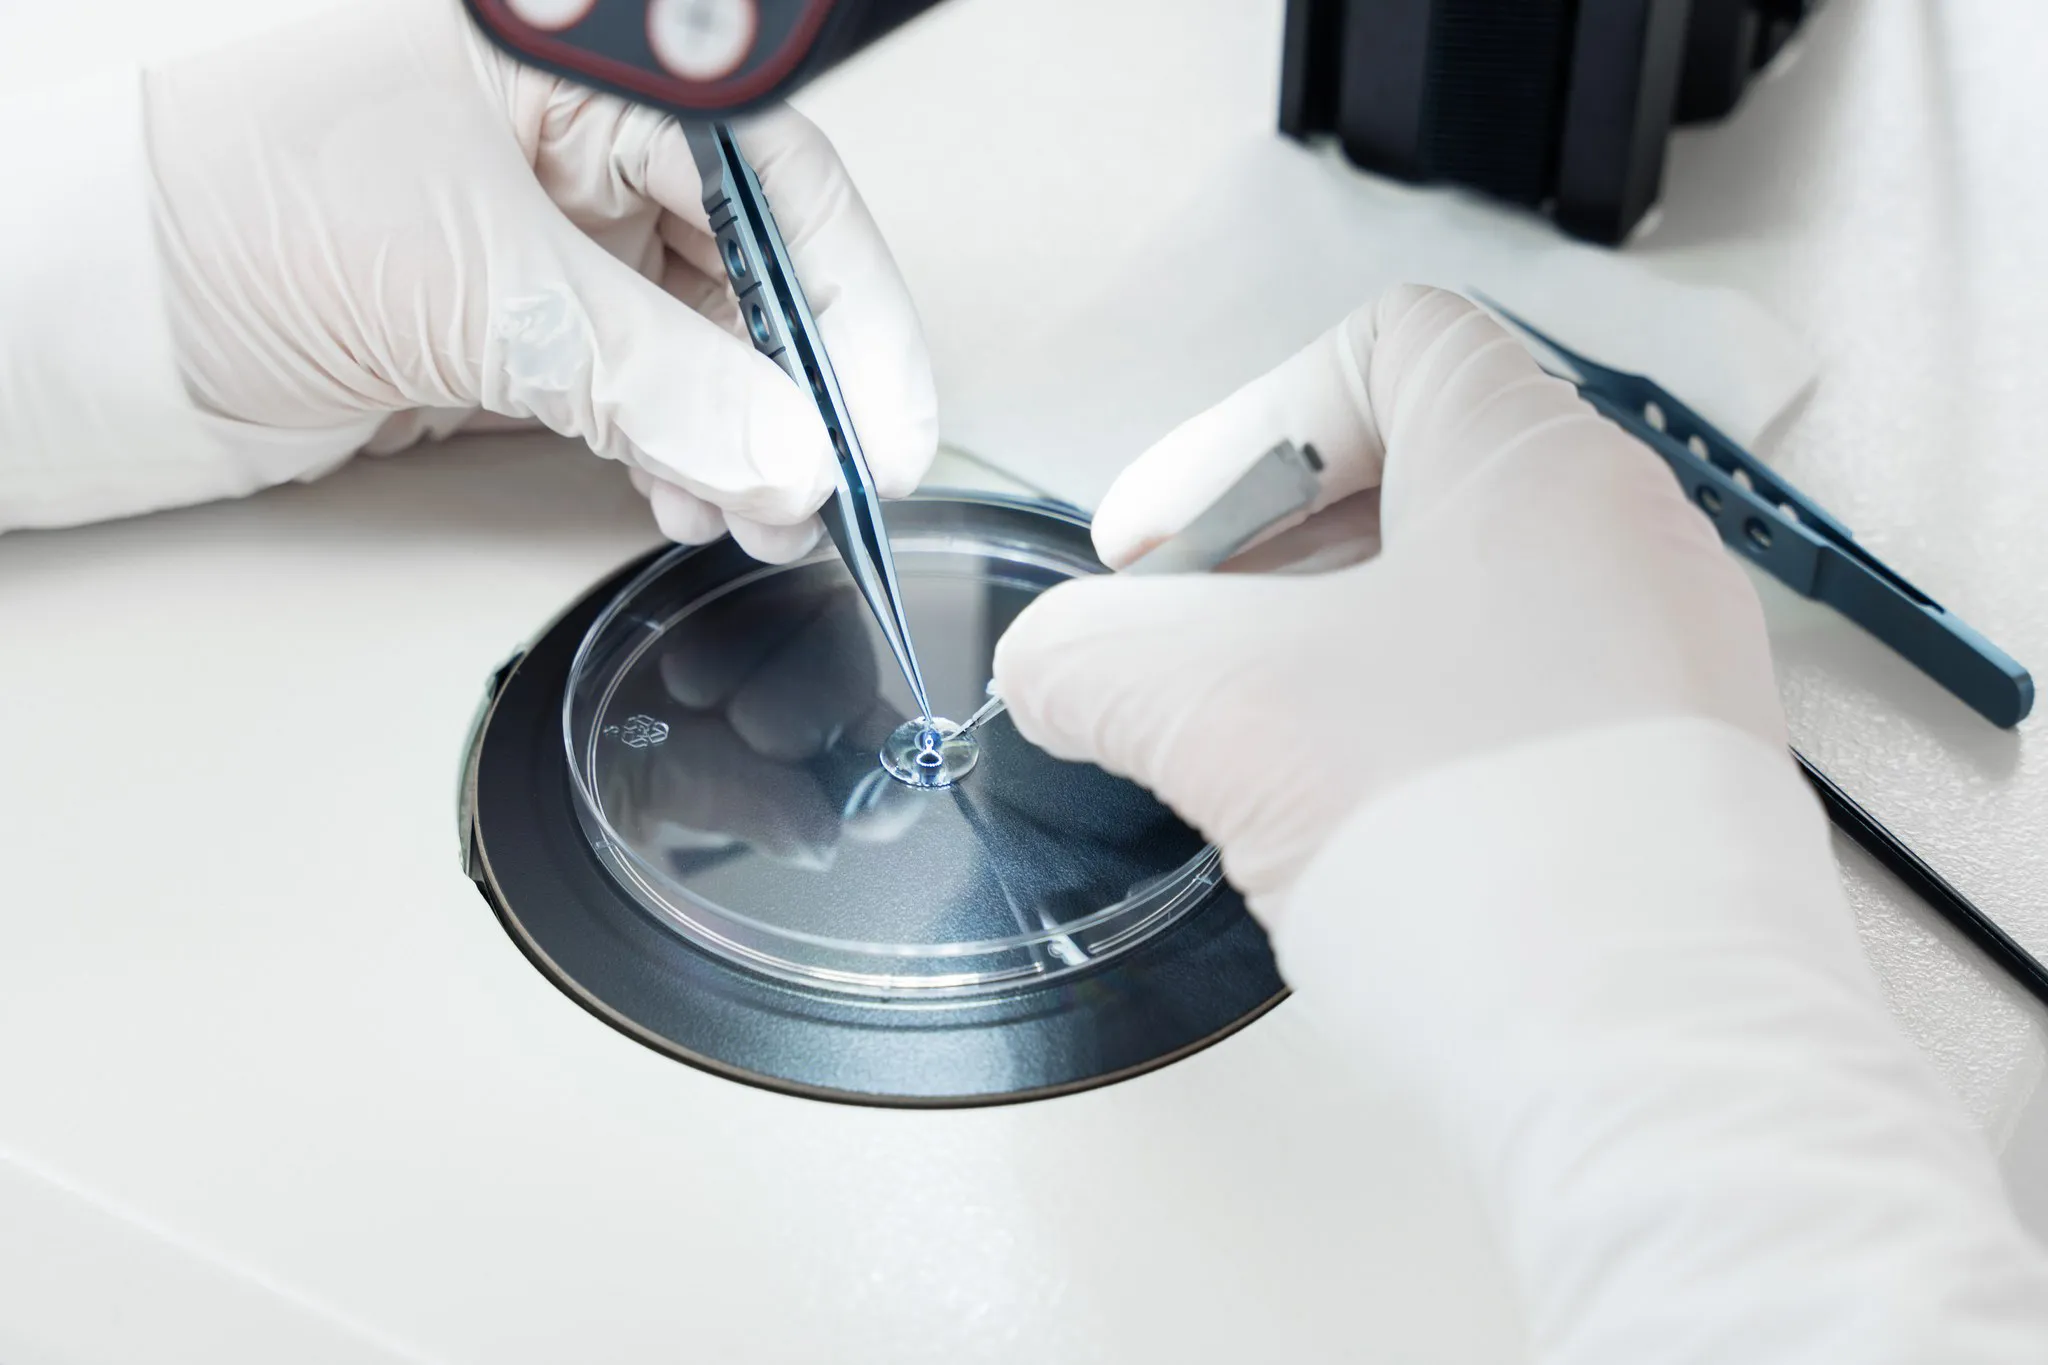

Early proof of concept and IND-enabling studies
Experimentica specializes in the development of preclinical ocular models and in testing ophthalmic drug candidates. Our teams offer deep scientific expertise and advanced technical platforms used in efficacy evaluation. We combine validated disease models with advanced imaging, functional, behavioral, and histological read-outs to generate reliable results and conclusions. Whether your goal is early candidate screening with a pilot study or a fully-powered, pivotal proof-of-concept study, we bring the right designs and insights as well as operational flexibility to meet the needs of sponsors.
Validated models with translational value
Our preclinical models are carefully developed and validated to replicate key aspects of ocular diseases in vitro and in vivo in mice, rats, and rabbits. This translational relevance enhances the predictive power of your nonclinical data and helps reduce downstream development risk. Our model portfolio includes:
- Retinal degeneration and neovascularization (wet AMD, dry AMD, diabetic retinopathy)
- Ocular inflammation and autoimmune uveitis
- Glaucoma, ocular hypertension, and neuroprotection
- Dry eye disease
Our experts advise our clients on model customization and study designs to align with their drug candidate’s route of administration and mechanism of action, enabling them to move from discovery through IND-enabling studies with efficiency and confidence.
Advanced drug delivery capabilities
We specialize in precise drug delivery across all major ocular compartments. Our scientists have a long track record administering a wide range of drug types, including small molecules, biologics, gene therapy, cell therapy, and sustained-release formulations. Noticeable routes of administration include eye drops, intravitreal, subretinal, suprachoroidal, intracameral, and subconjunctival injections of drugs, implants, and grafts.
Endpoints that matter
We offer an extensive suite of ocular read-outs designed to demonstrate therapeutic effects:
- Spectral domain optical coherence tomography (SD-OCT)
- Electroretinography (ERG)
- Fundus imaging & fluorescein angiography
- Intraocular pressure (IOP) measurement
- Histology, immunohistochemistry, and cell-specific staining
- AI-driven image analysis and morphometry
- Western Blot, ELISA, and qPCR
Our scientists will help you select the optimal endpoints based on your target, delivery route, and regulatory pathway.
From discovery to IND: a seamless collaboration
Experimentica is your scientific and strategic partner in the development of your Ophthalmology drug candidates. We collaborate with sponsors to shorten the path from early discovery through IND by aligning efficacy data with pharmacokinetics, safety pharmacology, and exploratory toxicology. Our multidisciplinary approach minimizes study redundancy, reduces timelines, and strengthens the overall nonclinical data package.

We are here to help
Whether you have a question about our preclinical models, capabilities, pricing or anything else, our team is ready to answer all your inquiries.
Related
DL-AAA–Induced Retinal Neovascularization and Chronic Leakage
DL-AAA-induced rabbit model enables long-term evaluation of retinal neovascularization and leakage with in vivo imaging and response to anti-VEGF therapy.
Learn moreHigh IOP-induced ischemia-reperfusion injury
Learn moreIn vitro tube formation assay (HUVECs)
The HUVEC tube formation assay quantifies angiogenesis in vitro by analyzing endothelial response to angiogenic signals and tube formation via imaging.
Learn moreLaser-induced Choroidal Neovascularization
Laser-induced CNV model mimics exudative AMD and supports evaluation of anti-angiogenic and anti-fibrotic therapies.
Learn moreOxygen-Induced Retinopathy
Oxygen-Induced Retinopathy model enables preclinical evaluation of retinal neovascularization and anti-angiogenic therapies.
Learn moreBlue Light Damage-induced Retinal Degeneration
The blue light-induced retinal damage model is used for studying phototoxicity-induced retinal degeneration, and is particularly relevant for conditions such as AMD.
Learn moreLaser-Induced Geographic Atrophy
Laser-induced geographic atrophy model replicates early GA pathology, enabling evaluation of dry AMD therapies using imaging, ERG, and histological analysis.
Learn moreSodium Iodate-Induced Retinal Degeneration
The sodium iodate-induced retinal degeneration model mimics AMD progression and supports evaluation of therapies using in vivo imaging techniques.
Learn moreWhite Light Damage-induced Retinal Degeneration
White light damage model mimics retinal degeneration, enabling preclinical evaluation of neuroprotective therapies.
Learn more


